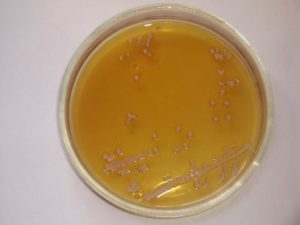
В моче крупинки оранжевые

С чем связано появление мочи оранжевого цвета: диагностика и возможные патологии

По цвету мочи определяют состояние здоровья пациента. Норма — это светло-желтая прозрачная урина, не имеющая неприятного запаха. Моча оранжевая становится при наличии какого-либо заболевания.
Но пугаться не стоит, так как бывают случаи, когда у совершенно здоровых людей изменяется цвет мочи.
Попробуем разобраться, как отличить состояние, требующее врачебного вмешательства, от безобидного кратковременного изменения окраски мочи.
Причины мочи оранжевого цвета
Моча оранжевого цвета может быть по разным причинам. Но не всегда есть повод для беспокойства. Иногда окрашивание урины происходит после употребления в пищу некоторых продуктов. Через день все приходит в норму.
Но существуют и симптомы, на которые нужно обратить внимание. ибо это может быть свидетельством возникшего недуга.
Причиной изменения цвета мочи могут быть:
- продукты питания;
- лекарственные препараты;
- болезни.
Рассмотрим каждую причину по отдельности
Оранжевый цвет у мочи часто появляется из-за употребления некоторых продуктов питания. Продукты окрашивают мочу с помощью красящих веществ, входящих в их состав. Овощи, фрукты, ягоды с большим содержанием каротина, витамина В и С — причина изменения цвета урины. Оранжевую окраску придают:
- морковь;
- облепиха;
- тыква;
- хурма;
- свекла;
- шиповник;
- все виды цитрусовых;
- малина;
- шпинат;
- петрушка;
- сельдерей;
- черная смородина.
Избыточное употребление моркови может привести к пожелтению не только урины, но и поверхности ладоней и ступней. Это явление носит временный характер и не опасно для здоровья. Через день цвет нормализуется.
Любители сладостей часто сталкиваются с потемнением урины, так как к этому приводит употребление избыточного количества сахара.
Натуральные продукты не представляют опасности для здоровья, а вот потемнение мочи после употребления напитков с химическими красителями должно насторожить. Для устранения симптомов нужно прекратить их пить.
Проблемы с обезвоживанием возникают у людей после тяжелых физических нагрузок: у спортсменов, дачников после работы на участке. Восстановление организма происходит после отдыха и восполнения объема воды.
А в случае с отравлениями или кишечными инфекциями требуется очистка организма, применение антибактериальных препаратов. Особенно часто проблема встречается у детей. Отсутствие лечения может привести к смертельному исходу.
Прием лекарственных препаратов является частой причиной изменения цвета мочи. Моча оранжевого цвета у женщин появляется после приема комплексов витаминов при беременности.
Почему моча оранжевая при заболеваниях? Цвет моче придает пигмент урохром, являющийся продуктом распада гемоглобина. Во время болезни его содержание увеличивается, урина изменяет окраску на более темную.
Когда нужно быть внимательным
Основные причины, которые должны послужить поводом для посещения врача:
- неприятный запах мочи;
- болезненность внизу живота;
- повышение температуры;
- рвота;
- рези и жжение при мочеиспускании;
- частые позывы к мочеиспусканию.
Сочетание этих симптомов с изменением цвета урины должно насторожить, так как это является свидетельством серьезного заболевания. Это могут быть:
- пиелонефрит — инфекционная болезнь почек, сопровождающаяся воспалением. Интенсивное размножение бактерий приводит к увеличению выработки продуктов жизнедеятельности, из-за чего моча приобретает темный цвет;
- камни в почках, которые провоцируют оксалаты, основные виновники рыжего цвета мочи;
- гематурия. При продвижении камней по мочевыводящим каналам повреждаются их поверхности, кровь попадает в мочу и изменяет ее цвет. Сопровождается болями в пояснице и в половых органах;
- гломерулонефрит — нарушение фильтрации и появление воспаления в клубочках почек. Цвет мочи становится ярко-оранжевым, появляются отеки на лице.
Моча по утрам содержит повышенное количество пигментов, так что потемнение ее в это время не всегда свидетельствует о нарушениях в организме. Это следствие накопления антидиуретического гормона, который дает возможность организму обходиться определенное время без мочеиспускания.
Моча рыжего цвета у мужчин свидетельствует о воспалении предстательной железы, явление часто встречается у пожилых. Красная урина может быть симптомом заболевания почек.
Покраснение мочи наблюдается у женщин при цистите. Это воспалительное заболевание мочевого пузыря. Причиной может стать переохлаждение. Лечение назначает врач.
Прием медицинских препаратов, таких как фенолфталеин, рифампицин, амидопирин, метронидазол, нафтол, фенилсалицилаты, вызывает резкое изменение цвета, вплоть до бурого. После завершения курса лечения урина приобретает желтоватый оттенок.
Сопутствующие симптомы
Если моча оранжевого цвета появляется при ухудшении самочувствия, нарушениях состояния здоровья, следует сразу обратиться к врачу.
Следующие симптомы должны насторожить пациента:
- повышение температуры;
- лихорадка;
- отеки на лице;
- кровь в урине;
- боли в области половых органов и поясницы;
- повышение давления.
При этом моча может быть красно-желтой.
Диагностика
Если моча стала оранжевого цвета и появились вышеназванные симптомы, нужно срочно обратиться к врачу. Только своевременная диагностика поможет определить характер заболевания и начать лечение.
Сначала необходимо сдать урину на анализы. После обследования и получения результатов врач поставит правильный диагноз и назначит лечение.
Что означает потемнение мочи, даст расшифровка анализов мочи и крови. Дополнительно проводят обследования печени, потому что некоторые ее заболевания приводят к изменению окраски мочи. Если заболевания печени не обнаружены, лечение проводится у уролога.
Лечение
Появление оранжевой мочи должно быть поводом для обращения к врачу. На основании проведенных исследований биохимического состава крови и мочи и другой диагностики будет назначено соответствующее лечение.
Беременные женщины должны проходить регулярное обследование у гинеколога.
Для составления полной картины заболевания врач отправит на УЗИ мочевого пузыря, почек, на обследование печени. При обнаружении болезни, связанной с мочеполовой системой, лечение будет проводить уролог.
Для эффективного лечения следует выявить первопричины недуга, которые привели к отклонениям от нормы. Возможно, что неправильное питание вызвало нарушения в организме. В таком случае назначается лечение, и изменяется рацион. Здоровье напрямую зависит образа жизни пациента.
В заключение
Если вы обнаружили, что моча ярко-оранжевого цвета, проанализируйте, что послужило причиной. Вспомните, что ели накануне, какие напитки употребляли. Возможно, некоторые лекарственные препараты вызвали изменение цвета.
Это не повод для беспокойства. После прекращения приема лекарственных средств цвет урины возвращается к норме.
Если у вас появились сопутствующие симптомы, свидетельствующие о нарушении в организме, самолечением заниматься нельзя, можно запустить болезнь. Если развивается воспалительный процесс, это может усугубить состояние.
Неправильное лечение приведет к переходу заболевания в хроническую форму, когда сложнее будет провести лечение. Поэтому так важно своевременно обратиться к врачу. Только правильное лечение поможет выздороветь.
А чтобы исключить появление заболеваний мочеполовой системы, ведите здоровый образ жизни, правильно распределяйте нагрузки на организм, чередуйте отдых с работой, не злоупотребляйте алкоголем, старайтесь правильно питаться.
Тогда ваша прозрачная моча светло-желтого цвета без запаха будет свидетельством отменного здоровья.
Песок в моче причины

Причины проявления мочекаменной болезни, и как следствие, песка в моче, обычно связаны с неправильным питанием и употреблением воды с не усваиваемыми примесями.
По мнению врачей, песок в мочевом пузыре появляется у любителей красного мяса коров, овец, бобовых, пьет регулярно воду, насыщенную множеством минеральных соединений.
Большое значение имеет способность организма переваривать пищу и выводить нежелательные вещества, индивидуальных физиологических особенностей пациентов. Если организм вырабатывает кислоту, конкременты растворяются и выводятся естественным путем.
Повышение уровня накапливающихся опасных веществ в моче, приводят к образованию песка и камней, в результате химических реакций в организме и физиологических изменений.
Подобные изменения провоцируются чрезмерной диетой, рядом принимаемых лекарств, особенностями климата, наследственностью, рядом других причин.
Выявить развитие мочекаменной болезни в начальной стадии очень сложно из-за отсутствия каких-либо характерных проявлений.
10 важных первичных симптомов
Очень важно обнаружить первичные симптомы появления песка в мочевом пузыре, об этом свидетельствует ряд факторов:
- Моча меняет цвет и начинает отвратительно пахнуть,
- частые позывы к мочеиспусканию,
- резкие болевые синдромы при мочеиспускании,
- появление в моче вкраплений белёсого и черного цвета,
- кровотечение при мочеиспускании,
- появление усталости,
- повышение давления
- вздутие живота
- избыточная потливость
- повышение температуры
У женщин, ввиду близкого расположения уретры и влагалища, болезнь сопровождается воспалительными процессами во влагалище, приводящими к хроническому циститу и уретриту.
Для мужчин характерен красный песок в мочи и кровяные выделения. При начале мочекаменной болезни почек из-за длинного мочеточника , мелких травм, порезов уретры от соприкосновения с кристаллами песка и камнями.
У детей, при начале болезни, следующие симптомы: повышенная утомляемость, частые позывы в уборную.
Если болезнь не выявить на начальных стадиях, она переходит в хроническую стадию.
Появление песка в мочевом пузыре может и не вызывать столь характерных симптомов. Если камней немного или они небольшого размера, их вывод не вызывает болезненных ощущений, возможен мало ощутимый дискомфорт в пояснице, учащение желания помочиться, появление рвотных позывов.
Состав мочи
При появлении песка состав мочи меняется. Потемнение и помутнение-характерный признак, но он может проявляется и при других почечных болезнях, не связанных с наличием песка в мочи. Требуется обязательное диагностирование состава мочи. Характерные факторы: повышенная плотность мочи, наличие частиц крови, слизистые и гнойные выделения.
Значительная концентрация крови в моче, окрашивает ее в бурый цвет, что свидетельствует о наличии крупных конкрементов в почках и повреждении мочеточника. Это явный признак развития мочекаменной болезни. Окрас мочи характерно отражает концентрацию песка.
Гнойные выделения свидетельствуют о наличии застойных явлений и воспалительных процессов в мочевом пузыре, наличии синегнойной палочки.
Конкремент это плотное образование более 1мм в диаметре из разных видов солей и белков. Конкременты могут достигать очень приличных размеров, самый большой обнаруженный камень составлял 17 см в диаметре и весил порядка 1кг.
Камни и песок в мочи различаются по объему и структуре. В песке субстанция солей и песка еще не образовалась в конкремент, а объем не превышает 0,9 мм.
Появление песка в мочи говорит о первом этапе мочекаменной болезни.
Проанализировав результаты обследования, можно определить наличие песка в моче. Если после тестов на присутствие в составе мочи оксалата кальция, уратов, мочевой кислоты выявляются минеральные соли, это говорит о нефролитиазе. Значит взвесь не расщепляется, а соединяется с вновь поступающим песком.
Наиболее совершенный метод определения присутствия песка в почках применение УЗИ исследования. В основном ультразвуком обнаруживают присутствие песка и камней. Где нет ультразвукового аппарата для диагностики, используют рентгенологическое обследование, но оно не очень надежно с точки зрения постановки верного диагноза.
Лечение при мочекаменной болезни зависит от состояния пациента и степени запущенности.
Для снятия текущего болевого синдрома принимают спазмолитический препарат, пьют большое количество воды с низким содержанием минералов малыми порциями, но до 3-х литров в день.
При возникновении болевых ощущений нежелательно сдерживать позывы посетить уборную, опорожнение уменьшит давление на мочевой пузырь.
Скрининг, профилактика
профилактика необходима при выявлении у пациента нефролитиаза и опасности возникновения прочих образований. Самой действенной профилактикой, в данном случае, будет поддержание баланса воды и строгое диетическое питание. Необходимо насыщение мочи щелочью, понизить осадок уратов.
- При обнаружении уратов необходимо снизить употребление мяса, соленой рыбы, бобов. Приоритетные овощи: морковь, редиска, картофель, сельдерей, цветная капуста, молочные продукты, разнообразные фрукты.
Необходимо насыщение мочи щелочью, понизить осадок уратов.
- При нахождении образования с фосфатами, не употреблять продукты с содержанием кальция.
- Если обнаружены образования камней из цистина необходимо употреблять в пищу молоко, творог, сметану, зелень, не есть продукты из мяса
- Если обнаружены камни оксалата, запрещены: ревель и щавель, шпинат, шоколад, чай, кофе.
Методы лечения
Для лечения мочекаменной болезни пациенты обращаются как к классической медицине, так и к нетрадиционной:
- Лечение препаратами, создающими в почках среду с большой кислотной концентрацией без агрессивного воздействия на стенки внутренних органов. В подобной среде камни растворяются и естественным путем выводятся из организма. Применение таких медикаментозных препаратов позволяет снизить количество соляных отложений на стенках каналов.
- Ультразвуковое воздействие и дробление аппаратом, генерирующим звуковые высокочастотные волны, которые виброимпульсами разрушают конкременты. Такой метод безопасен, лечение болезни эффективное, возможны лишь побочные явления в виде небольшого воспаления, которое локализуется без применения препаратов через несколько дней.
- Хирургическое вмешательство применяется в редких случаях обострения болезни почек, когда размер образований достигает 5 см и есть большой риск закупорки каналов моче выведения. При невмешательстве есть большой риск возникновения почечной недостаточности и непоправимых последствий для организма.
Когда болезнь диагностирована на ранних стадиях и нет еще больших камней, лишь песок в моче, возможно избежать амбулаторного лечения и ограничиться диетой с правильным питанием, исключив жирную, соленую пищу с большой концентрацией минералов, мясные продукты, бобы, полуфабрикаты с химическими красителями. Желательны регулярные физические нагрузки, употребление большого количества жидкости и регулярный контроль за соляным балансом здоровый образ жизни.
Причиной заболеваний мочеполовой системы и почек часто является избыточный вес.песок в моче
Песок в моче: факторы, причины, признаки патологии, профилактика

Почки в человеческом организме исполняют функции фильтрации. Обычно песок в моче формируется в случае неполного вывода отходов.
Из-за узкого мочевого канала и особенного строения мочевой системы чаще всего данная патология встречается у мужчин.
Песок в небольших количествах не проявляется неприятными ощущениями и может выводиться самостоятельно. Крупные частицы могут вызвать болезненность и другие неприятные ощущения.
Что означает присутствие песка в моче
В моче здорового человека содержится большое количество разных веществ в растворенном виде. В таком виде они и выводятся из организма по мочеточнику. Этот процесс протекает безболезненно.
При нарушениях коллоидного или кислотно-щелочного баланса меняется процентное содержание солей в моче. Появляется возможность их кристаллизации и оседания в виде крупинок песка, который накапливается в почках. Со временем он может соединяться в крупные образования – почечные камни.
Если обнаружен песок в моче, то это может свидетельствовать о развитии нефролитиаза.
Основные симптомы формирования камней: невыносимая боль, кровотечения из стенок мочевого канала, блокировка потока мочи.
Причины образования песка в мочевом пузыре и моче
Песок в моче выглядит как мутный осадок, а в некоторых случаях может содержать кровяные примеси. Существует большое количество причин образования песка. Основные причины — это нарушение водно-солевого баланса и неправильное питание.
Внутренние факторы
Главными причинами, вызывающими патологии в почках, являются воспаления и хронические болезни, в результате которых формируется песок.
Через некоторое время он может кристаллизоваться в камни более крупных размеров. При этом происходят сбои в функциональности мочевой системы.
В моче наблюдается повышение уровня белка и лейкоцитов, а это может указывать на формирование мочекаменной болезни.
Песок в моче у детей возникает в результате врожденных аномалий органов мочевой системы. Такие патологии вызывают неправильное передвижение мочи. Обычно песок в моче царапает стенки мочеточника, в результате чего возникают воспаления.
Формирование камней бывает:
- Первичное. Камни возникают в мочевом пузыре в результате нарушений естественного оттока мочи. Застаиваясь, урина концентрируется и образует налет на эпителии мочевого пузыря.
- Вторичное. Новообразования формируются в почках в результате нарушенного оттока мочи.
Кроме вышеперечисленных внутренних причин формирования песка существуют и внешние факторы.
Внешние факторы
Среди внешних причин возникновения песка в моче следует отметить следующие:
- тяжелая физическая работа в условиях повышенной температуры воздуха,
- малоподвижный образ жизни,
- не контролированный прием минеральных вод,
- употребление белковой пищи в большом количестве,
- повышенное потоотделение,
- недостаточное употребление жидкости.
Песок образуется в результате патологических процессов обмена разного характера. Одной из причин также может стать подагра.
Признаки патологии
Симптомы появления мелкого песка обычно минимальные.
А формирование крупных новообразований могут вызвать последующие симптомы:
- Сильные болевые ощущения во время мочеиспускания, вызванные травмированием мочевыводящих каналов. Кроме того, может наблюдаться острая боль в поясничном отделе.
- Зуд, а также чувство жжения в зоне уретры, возникающие после мочеиспускания. Эти симптомы проявляются в результате раздражения уретры солями.
- Отеки нижних конечностей могут свидетельствовать о почечной недостаточности. Возникают в результате несвоевременного лечения болезни.
- Затрудненное опорожнение и полная блокировка выхода мочи. Эти симптомы появляются в результате скопления песка в узкой части мочеиспускательного тракта и его закупорки.
- Появление кровяных примесей в моче. Передвигаясь по мочеиспускательным каналам, песок может травмировать сосуды, и моча окрашивается кровью.
У детей может наблюдаться повышение температуры в результате воспаления.
Диагностика заболевания
Осадок в моче может появиться как у мужчин, так и у женщин. Кроме того, данная патология встречается и в детском возрасте. Для постановки точного диагноза врач сначала проводит опрос больного.
Наличие песка пациент может заметить при мочеиспускании. Однако о наличии камней можно узнать спустя некоторое время, поскольку они способны прикрепляться к стенкам почек.
В этом состоянии они не препятствуют выводу мочи, и через какое-то время все равно попадают в канал и закупоривают его.
Самый результативный метод диагностики наличия песка – это УЗИ органов мочевой системы. Кроме того, наличие песка показывают анализы мочи и крови. В некоторых случаях врач может назначить рентгенологическое исследование.
Основные методы терапии
Лечение песка в моче напрямую завит от состояния пациента. Для снятия болезненности можно принять спазмолитическое лекарство.
Современная медицина предлагает следующие основные методы лечения патологии.
Медикаментозное лечение
Данный метод основан на приеме медикаментов для создания кислотной среды. Медикаменты способствуют растворению камней и их выводу природным путем. Эти препараты стимулируют и снимают соляные отложения в мочевых каналах.
Ультразвуковое разрушение
При помощи данного метода камни разрушаются специальным аппаратом, генерирующим высокочастотные волны. При процедуре внутренние органы не травмируются. Может наблюдаться небольшое воспаление, которое через несколько дней проходит самостоятельно.
Хирургическое удаление
Данный метод применяется, когда размеры новообразований превышают в диаметре 5 см. В таких случаях существует риск блокирования мочевых каналов и возникновения непоправимых последствий.
Особенности питания
В случаях, когда песок выходит самостоятельно и отсутствуют конкременты, врач рекомендует придерживаться специальной, индивидуальной диеты и регулярно проводить физические упражнения. Категорически запрещен прием мясного, жирного, бобовых, полуфабрикатов с красителями, минералами и карбонатами. Обычно облегчение наступает через несколько недель.
Профилактические меры для предотвращения патологии
Чтобы избежать возникновение песка в моче, необходимо придерживаться следующих простых правил:
- вести здоровый способ жизни,
- отказаться от вредных привычек,
- сбалансированно питаться,
- контролировать массу тела.
А также необходимо обратить внимание на употребляемую воду. Рекомендуется фильтровать воду из центрального водопровода.
Как известно, любое заболевание легче предупредить, чем излечить. Поэтому необходимо внимательно относиться к своему здоровью, избегать стрессовых ситуаций, переохлаждения, употреблять продукты, богатые витаминами. А при малейших признаках рекомендуется посетить врача для консультации, чтобы избежать серьезных осложнений.
Оранжевые крупинки в моче

Общий анализ мочи является одним из наиболее распространенных исследований, которое назначают практически каждому пациенту минимум раз в год. За результатами анализа мочи врачи могут судить о работе почек и состоянии мочевыделительной системы. Также изменения показателей мочи могут свидетельствовать о нарушениях работы печени, поджелудочной железы и эндокринной системы.
Еще до проведения исследований в лаборатории, по внешним характеристикам выделений можно сделать предварительные выводи о состоянии организма человека.
В норме моча взрослого человека и ребенка прозрачная, без каких либо примесей. Цвет выделений изменяется на протяжении дня в зависимости от количества употребляемой жидкости. Моча после периода сна обычно более насыщена и приобретает темный соломенный оттенок. На протяжении дня у человека выделяется светло-желтая моча.
По консистенции моча напоминает воду. Для мочи характерен специфический запах, который обусловлен выделением продуктов обмена веществ. В норме запах не слишком едкий и резкий. При появлении сильного аммиачного или ацетонового запаха можно заподозрить патологию мочевыделительной системы.
При появлении гнилостного запаха выделений также необходимо сдать мочу не исследование.
Любые примеси и включения в моче являются патологией и свидетельствуют о нарушении работы мочевыделительной системы. Моча с хлопьями может выделяться прямо во время мочеиспускания, а также хлопья могут выпадать в осадок после того, как моча немного постоит. Хлопья в моче при разных заболеваниях могут отличаться по цвету.
Цвет примесей в моче:
- белые хлопья;
- желтые хлопья;
- зеленые хлопья;
- коричневые хлопья;
- красные сгустки.
Причины появления белых примесей в моче
Хлопья в моче являются симптомом болезней почек, мочевого пузыря или мочевыделительных путей. Только по внешним характеристикам трудно определить причины появления примесей в моче, но они позволяют заподозрить болезнь и продолжить обследование.
Белые хлопья в моче обычно являются сгустками слизи и клеток эпителия. Воспалительные процессы в мочевыделительной системе приводят к повышению продукции слизи.
На место воспаления приходит большое количество лейкоцитов, эпителий стенок мочевыделительного канала отслаивается и все это попадает в мочу.
Причины появления белых хлопьев:
- уретрит;
- цистит;
- простатит;
- гинекологические заболевания;
- нефрит беременных.
Острый уретрит сопровождается болезненными ощущениями во время мочеиспускания. Больные жалуются на учащение позывов к мочеиспусканию. Чувства жжения и рези не проходит после похода в туалет. У мужчин боли могут отдавать в мошонку и пах. Уретрит может возникать в результате переохлаждения и травмы. Причины уретрита могут быть связаны с инфекциями, которые передаются половым путем.
Цистит чаще возникает у женщин, чем у мужчин. Это связано с анатомическими особенностями строения женской половой и мочевыделительной систем. Цистит сопровождается довольно сильными болями внизу живота. Позывы к мочеиспусканию учащены и болезненны. В некоторых случаях может подниматься температура тела.
У мужчин белые хлопья в моче могут свидетельствовать о воспалении предстательной железы. При простатите у мужчин учащаются ночные позывы к мочеиспусканию. Со временем может нарушаться потенция и развиваться недержание мочи. Мужчин периодически беспокоят боли в промежности.
У женщин белые хлопья могут попадать в мочу из влагалища. Вагиниты и вульвовагиниты у женщин вызывают неприятные жгучие ощущения во влагалище. В некоторых случаях женщин беспокоит зуд. Во время полового акта женщины жалуются на боль и сухость во влагалище. Для того чтобы предотвратить попадание выделений из влагалища в мочу, рекомендуют при заборе анализов использовать гигиенический тампон.
При нефрите у беременных женщин также могут появляться различные включения в моче. При обнаружении любых примесей и нехарактерных соединений, беременной женщине необходимо обратиться к гинекологу и сдать дополнительные анализы.
Белые хлопья могут появляться у ребенка после длительного удержания мочи. У мальчиков и мужчин утренняя порция мочи может содержать белые включения – частички спермы, которые попали в мочу.
Желтые и зеленые хлопья в моче
Желтые и зеленые включения в выделениях обычно свидетельствуют о бактериальной инфекции почек и мочевого пузыря. При бактериальной инфекции образуется гной, который попадает в мочу. Выделения в таких случаях имеют неприятный резкий, гнилостной запах.
Для того чтобы определить причины, почему в моче появились гнойные хлопья, больному проводят ряд важный исследований. Для оценки состояния почек человеку проводят УЗД органов мочевыделительной системы. Для выявления возбудителя болезни необходимо провести посев образцов на питательные среды.
Болезни, при которых появляется гной в моче:
- пиелонефрит;
- бактериальный уретрит;
- венерические болезни;
При пиелонефрите состояние человека резко ухудшается. Бактериальная инфекция вызывает повышение температуры тела, слабость, вялость и упадок сил. Одним из симптомов пиелонефрита является интенсивная ноющая боль в пояснице
Бактериальный уретрит также может вызывать повышение температуры тела. Уретрит вызывает неприятные режущие ощущения в половых органах. Человека беспокоит резь и боль во время мочеиспускания.
Венерические болезни передаются половым путем и вызывают поражение мочеполовой системы. Такие заболевания как гонорея и сифилис вызывают обильное образование гноя и слизи. Для диагностики венерических заболеваний необходимо провести дополнительные анализы, мазки из гениталий и исследование крови на антитела к возбудителям инфекции.
У ребенка при бактериальной инфекции почек появляется жар, сильно повышается температура тела и без лечения может развиваться сепсис. При любых изменениях выделений ребенка необходимо отвести на консультацию к педиатру.
Коричневые хлопья в моче
При некоторых заболеваниях моча обретает цвет мясных помоев. Такой характерный цвет образуется в результате выделения большого количества белка, лейкоцитов, слизи и крови, которая окисляется и темнеет. Выделения цвета мясных помоев является симптомом характерным для гломерулонефрита.
Гломерулонефрит это двустороннее поражение почек, которое развивается по принципу инфекционно-аллергического заболевания. Провоцирующими факторами могут служить сильное переохлаждение или стрептококковая инфекция верхних дыхательных путей.
При легком течении гломерулонефрита изменения мочи могут быть единственным симптомом болезни. Более тяжелые случаи могут сопровождаться серьезными нарушениями. При гломерулонефрите с мочой человек теряет большое количество белка, что вызывает развитие отеков на лице и конечностях. Также воспаление почек может вызывать боль в области поясницы с двух сторон.
Анализы для диагностики гломерулонефрита:
- общий анализ мочи;
- суточный анализ мочи;
- общий анализ крови;
- УЗД почек.
Красные сгустки в моче
Сгустки свежей крови в моче обычно очень пугают человека. Кровь в выделениях может появляться на фоне абсолютного здоровья, но в большинстве случаев сопровождается и другими симптомами.
Причины появления красных сгустков:
- геморрагический цистит;
- мочекаменная болезнь;
- опухоль почки;
- опухоль мочевого пузыря.
При остром цистите человека беспокоит сильная боль внизу живота. В мужчин болевые ощущения отдают в пах и мошонку. Цистит сопровождается повышением температуры. Во время мочеиспускания человек чувствует сильную режущую боль. Цистит может возникать после сильного переохлаждения или попадания инфекции в мочевыделительный канал.
При мочекаменной болезни в почке образуются камни. При их отхождении они могут травмировать мелкие сосуды, и кровь будет попадать в мочу.
Отхождение камней из почек сопровождается сильными болевыми ощущениями в области поясницы и паха. Чувство боли иногда настолько сильное, что может вызывать тошноту и рвоту.
В тяжелых случаях камни могут перекрывать мочевыводящие пути и вызывать задержку мочи.
Опухоли почек и мочевого пузыря на первых стадиях обычно протекают бессимптомно. Но в некоторых случаях возможно периодическое попадание крови в образцы мочи. Опухоли мочевого пузыря могут вызывать нарушение или задержку мочеиспускания.
Красные частички в моче
Моча может поведать о протекании в человеческом организме различных заболеваний, поэтому, когда назначается обследование, данный вид диагностики стоит, практически, на первом месте.
Во время проведения исследования учитываются все показатели биологической жидкости: ее удельный вес, прозрачность, запах, плотность, кислотность и пр., но самый яркий показатель протекания в организме инфекции – изменение цвета.
Окрашивание урины в красные оттенки указывает на самые разные недуги, начиная от обычной инфекции, протекающей в области мочеполовых путей и заканчивая онкологическими процессами.
Что происходит с человеческим организмом и каким заболеванием страдает пациент, должен выяснять врач. Тем не менее каждый человек обязан знать, по какой причине в его моче возникают кровяные вкрапления. Тогда ему легче будет свыкнуться с мыслью, что данный признак является очень серьезным и нужно показаться специалисту.
Гематурия
Наличие вкраплений крови в биологической жидкости называется гематурией. В свою очередь, данная патология делится на:
- Микрогематурию – когда невозможно визуально определить наличие крови в моче. Ее выявление происходит посредством применения лабораторного оборудования.
- Макрогематурию. В этом случае, кровь можно увидеть не прибегая к специальным диагностическим средствам. Если пациент соберет биологический материал в баночку, он явственно сможет наблюдать, как в урине будут присутствовать красные частички.
При гематурии моча может окрашиваться в различные оттенки красного. Она может быть розовой, ярко-красной или темно-коричневой.
Причины отклонения
Причины того, что урина приобретает неестественный для нее цвет, могут быть самые разные: как безобидные, так и нет. Следы крови могут проникнуть в биологическую жидкость во время ее прохождения по мочевым путям:
- из полости почечного органа, когда урина подвергается фильтрации;
- из мочеточников;
- из полости мочевого пузыря;
- из уретрального канала.
Невозможно без проведения полноценного диагностического исследования выявить причину возникновения данной патологии, так как на сегодняшний день зарегистрировано более сотни факторов, провоцирующих окрашивание мочи в красные оттенки.
Самыми наиболее распространенными причинами являются:
- Инфекционные процессы, протекающие в организме человека.
В большинстве случаев, они возникают вследствие заражения мочевой системы различными бактериями или инфекциями. К заболеваниям, при которых урина приобретает нехарактерный для нее красный цвет, относятся: цистит, почечный туберкулез, уретрит.
- Последствия получения травмы в области лобка, живота или поясничного отдела.
Кровь в биологической жидкости будет выявляться при травматизации почечного органа или мочевого пузыря. Травмирование может быть, как тупым, так и проникающим.
К самым безобидным причинам развития гематурии, можно отнести занятия бегом с полностью опорожненным мочевым.
Во время этого процесса, его стенки будут подвергаться сильному трению, что станет причиной незначительного выделения кровяных вкраплений.
- Наличие конкрементов в почках или в мочевом.
Зачастую пациент даже не догадывается, что они присутствуют в его мочевой системе, поэтому не предпринимает никаких действий, направленных на лечение. Камни потихоньку увеличиваются в размерах и, когда они становятся большими, начинают соприкасаться друг с другом и провоцировать травмирование стенок внутренних органов.
В итоге происходит выделение небольшого количества крови, которая выходит вместе с мочой. Кроме того, конкременты являются сильными провокаторами развития инфекционных процессов, а также чрезмерно раздражают слизистые ткани мочеточников и почек, что также является причиной выделения крови.
- Появление новообразований злокачественного характера в области мочевой системы.
Если пациент не страдает никакими ярко-выраженными симптомами, кроме появления кровяных сгустков, он перешел рубеж сорокалетия и не подвергался травматизации, вполне возможно, ему стоит провериться на наличие новообразований в области мочевого. Рак мочевого – это самая распространенная проблема, которая затрагивает людей старше 40 лет. Если его выявить вовремя, назначается оперативное вмешательство.
В случае, когда опухоль затрагивает все мышечные слои и начинаются метастазы, проводятся химиотерапевтические мероприятия или удаление мочевого органа.
Если же кровь в биологической жидкости напоминает больших червей, вполне возможно, пациент страдает раком почки.
Менее распространенные заболевания:
- доброкачественные новообразования, также становятся причиной выделения крови в мочу. В этом случае, у пациентов диагностируют кисту почки;
- патологии, характеризующиеся плохой свертываемостью крови: анемия, лейкемия и пр.;
- сосудистые заболевания: тромбоз почечной вены;
- почечные недуги: пиелонефрит, гломерулонефрит, папиллярный некроз и пр.
Безобидные причины
Кроме всех вышеописанных причин, есть и другие, которые не несут серьезной угрозы пациенту. К ним относятся:
- Употребление продуктов, способствующих окрашиванию мочи в красные оттенки. К ним относится черника, свекла, голубика, красный виноград, гранат, ревень и пр.Когда пациент прекратит употреблять эти продукты, цвет его урины придет в норму.
- Выделение небольшого количества крови в биологическую жидкость может быть спровоцировано различными медикаментозными препаратами. Способностью повреждать мелкие кровеносные сосуды и раздражать ткани, обладают некоторые наркотические вещества, обезболивающие, химиотерапевтические, спазмолитические, противовоспалительные и пр. препараты. К таким лекарствам можно отнести аспирин, циклофосфан, пенициллин и др.
У женщин
В основном, причиной выделения крови с уриной у женщин, возникает вследствие протекания инфекционных процессов в области мочевыводящей системы. Женский уретральный канал устроен несколько иначе, чем у мужчин. Он короткий и широкий, что позволяет инфекциям, бактериям и болезнетворным микроорганизмам попадать в мочеполовые пути.
Так, например, циститом женское население болеет намного чаще, нежели мужское и все из-за того, что их мочеиспускательный канал имеет свои особенности. При цистите возникает масса неприятных и болезненных симптомов:
- боли при мочеиспускании;
- нескончаемое желание опорожнить мочевой;
- дискомфорт в области поясничного отдела и внизу живота;
- слабость и озноб.
Если женщина принимает противозачаточные препараты гормонального характера, то они также могут спровоцировать нарушения кровеносных сосудов в мочевыводящей системе, что станет причиной выделения небольшого количества крови.
У мужчин
В основном, гематурия у мужчин может быть спровоцирована заболеваниями предстательной железы. К наиболее безобидным недугам относится аденома простаты, к опасным – рак предстательной железы.
Появление кровяных сгустков в биологической жидкости может возникнуть вследствие сильного физического перенапряжения. Как правило, данный симптом пропадает самостоятельно, когда мужчина получит полноценный отдых.
У детей
Причиной гематурии у детей, также становятся инфекционные процессы, протекающие в области мочеполовых путей. При воспалении почек или мочевого пузыря, ребенок будет жаловаться на:
- болевые ощущения при испускании биологической жидкости;
- постоянные позывы опорожнить мочевой;
- дискомфорт в области низа живота или поясницы.
Еще одна патология, которая выявляется у большинства маленьких детей – гломерулонефрит.
Кроме того, есть ряд и других причин, вызывающих гематурию у детей. К ним относятся:
- предрасположенность на наследственном уровне к почечным патологиям;
- неправильный уход за детскими, интимными органами;
- получение ребенком травмы в области уретры во время игры.
Когда пациент замечает в своей моче явно-выраженные признаки крови, следует незамедлительно обратиться к врачу, который назначит диагностику для определения патологии. Лечебные мероприятия будут зависеть от выявленного заболевания. Во время терапии могут быть назначены антибиотики, противовоспалительные, антибактериальные и обезболивающие препараты.